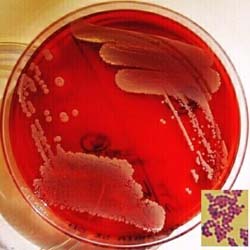

Tụ cầu vàng - Staphylococcus aureus
Đặc điểm
Hình dạng và kích thước
Tụ cầu là những cầu khuẩn, có đường kính từ 0,8- 1,0 µm và đứng thành hình chùm nho, bắt màu Gram (+), không có lông, không sinh nha bào, thường không có vỏ.
Nuôi cấy
Tụ cầu vàng thuộc loại dễ nuôi cấy, phát triển được ở nhiệt độ 10- 450C và nồng độ muối cao tới 10%. Thích hợp được ở điều kiện hiếu và kỵ khí.
- Trên môi trường thạch thường, tụ cầu vàng tạo thành khuẩn lạc S có đường kính 1-2 mm, nhẵn. Sau 24h ở 370C, khuẩn lạc thường có màu vàng chanh.
- Trên môi trường thạch máu, tụ cầu vàng phát triển nhanh, tạo tan máu hoàn toàn. Tụ cầu vàng tiết ra 5 loại hemolysin: α, β, δ, ε, γ.
- Trên môi trường canh thang: tụ cầu vang làm đục môi trường, nếu để lâu nó có thể lắng cặn.
Khả năng đề kháng
Tụ cầu vàng có khả năng đề kháng với nhiệt độ và hóa chất cao hơn các vi khuẩn không có nha bào khác. Nó bị diệt ở 800C trong 1h (các vi khuẩn khác thường bị diệt ở 600C trong 30 phút).
Tụ cầu vàng cũng có thể gây bệnh sau một thời gian dài tồn tại ở môi trường
Sự kháng kháng sinh  | |
Staphylococcus aureus | dưới kính hiển vi điện tử |
Sự kháng kháng sinh của tụ cầu vàng là một đặc điểm rất đáng chú ý. Đa số tụ cầu kháng lại penicillin G do vi khuẩn này sản xuất được men penicillinase nhờ gen của R.plasmid. Một số còn lại kháng lại được methicillin gọi là methicillin resistance S. aureus (MRSA), do nó tạo ra được các protein gắn vào các vị trí tác động của kháng sinh. Hiện nay một số rất ít tụ cầu còn đề kháng được với Cephalosporin các thế hệ. Kháng sinh còn được dùng trong các trường hợp này là vancomycin
Tính chất hóa học
Tụ cầu có hệ thống enzyme phong phú, những enzyme được dùng trong chẩn đoán:
- Coagulase có khả năng làm đông huyết tương người và động vật khi đã được chống đông. Đây là tiêu chuẩn quan trọng nhất để phân biệt tụ cầu vàng với các tụ cầu khác. Coagulase có ở tất cả các chủng tụ cầu vàng.
- Catalase (+). Catalase có ở tất cả các tụ cầu mà không có ở liên cầu
- Lên men đường mannitol
- Desoxyribonuclease là enzyme phân giải ADN
- Phosphatase
Phân loại
Phân loại khoa học
Về phân loại khoa học Staphylococcus aureus được xếp vào:
- Giới: Eubacteria
- Ngành: Firmicutes
- Lớp: Cocci
- Bộ: Bacillales
- Họ: Staphylococcaceae
- Giống: Staphylococcus
- Loài: S. aureus
- Tên khoa học: Staphyococcus aureus Rosenbach 1884
Phân loại theo kháng nguyên
Các tụ cầu có nhiều loại kháng nguyên: protein, polysaccharid, acid teichoic của vách. Nhưng dựa vào kháng nguyên, việc định loại rất khó khăn. Các kháng nguyên trên bề mặt tế bào được quan tâm:
- Acid teichoic: là kháng nguyên ngưng kết chủ yếu của tụ cầu và làm tăng tác dụng hoạt hóa bổ thể. Đây còn là chất bám dính của tụ cầu vào niêm mạc mũi. Acid này gắn polysaccharid vách tụ cầu vàng. Đây là kháng nguyên O.
- Protein A: là những protein bao quanh bề mặt vách tụ cầu vàng và là một tiêu chuẩn để xác định tụ cầu vàng. 100% các chủng tụ cầu vàng có protein này
- Vỏ polysaccharid: một số ít chủng S. aureus có vỏ và có thể quan sát được bằng phương pháp nhuộm vỏ. Lớp vỏ này bao gồm nhiều tính đặc hiệu kháng nguyên và có thể chứng minh được bằng phương pháp huyết thanh học. Vỏ của tụ cầu cũng có tác dụng chống thực bào bởi vỏ đã che phủ peptidoglycan của vách, làm cho bổ thể này không có chỗ bám để hoạt hóa theo con đường tắt.
Phân loại bằng phage
Các phương pháp phân loại dựa trên kháng nguyên của tụ cầu là rất khó khăn, vì vậy việc phân loại tụ cầu vàng là chủ yếu dựa trên phage
- nhóm I: 29, 52, 52A, 79, 80.
- Nhóm II: 3A, 3B, 3C, 55, 71.
- Nhóm III: 6, 7, 42E, 47, 53, 54, 75, 77, 83A, 84, 85.
- Nhóm IV: 42D.
Khả năng gây bệnh: Nhiễm độc thức ăn và viêm ruột cấp
Ngộ độc thức ăn tụ cầu có thể do ăn uống phải độc tố ruột của tụ cầu hoặc do tụ cầu vàng vốn cư trú ở đường ruột chiếm ưu thế về số lượng. Nguyên nhân là sau một thời gian dài bệnh nhân dùng kháng sinh có hoạt phổ rộng, dẫn đến các vi khuẩn chí bình thường của đường ruột nhạy cảm kháng sinh bị tiêu diệt và tạo điều kiện thuận lợi cho tụ cầu vàng tăng trưởng về số lượng.
|
Phân lập Staphylococcus aureus trên thạch máu |
Triệu chứng của ngộ độc thức ăn do tụ cầu thường rất cấp tính. Sau khi ăn phải thức ăn nhiễm độc tố tụ cầu từ 2-8h, bệnh nhân nôn và đi ngoài dữ dội, phân lẫn nước, càng về sau phân và chất nôn chủ yếu là nước. Do mất nhiều nước và điện giải có thể dẫn tới shock. Ngoài nguyên nhân là tụ cầu, một số trường hợp có thêm vai trò của Clostridium difficile, sau khi dùng kháng sinh phổ rộng.
Miễn dịch
Miễn dịch thu được với tụ cầu nói chung là thấp. Hàng rào tế bào tự nhiên, trong đó tế bào thực bào đóng vai trò quan trọng nhất
- Đáp ứng miễn dịch qua trung gian tế bào có xảy ra với việc tiết ra các lymphokin và hoạt hóa đại thực bào. Tuy vậy nhưng đã không làm tăng được sự diệt khuẩn.
- Miễn dịch dịch thể cũng xuất hiện để chống lại các yếu tố độc lực, nhưng nó không có vai trò bảo vệ ý nghĩa, vì tụ cầu ít tiếp xúc với kháng thể hoặc tế bào sản xuất kháng thể.
Chẩn đoán vi khuẩn học
Phân lập xác định tụ cầu là việc cần thực hiện và không mấy khó khăn. Thạch máu là môi trường thích hợp để phân lập, nơi tụ cầu phát triển rất tốt. Có thể sử dụng môi trường lựa chọn chứa 7,5% NaCl, đường mannitol và có thể có cả kháng sinh chống vi khuẩn Gram (-) (khi bệnh phẩm có nhiều loại vi khuẩn). Sau đó xác định các tính chất:
- Khuẩn lạc S, màu vàng nhẹ
- Tụ cầu Gram (+) đứng thành hình chùm nho
- Coagulase (+)
- Mannitol (+)
- Kháng novobiocin
- Phosphatase (+)
- Catalase (+)
Phòng bệnh và điều trị
 |
Hình thể Staphylococcus aureus |
Phòng bệnh
Phòng bệnh nhiễm khuẩn tụ cầu chủ yếu là vệ sinh môi trường, quần áo và thân thể. Vì tụ cầu có rất nhiều ở những nơi này, đặc biệt là vệ sinh môi trường bệnh viện để chống nhiễm khuẩn bệnh viện
Điều trị
Kháng sinh trị liệu chống nhiễm khuẩn tụ cầu là biện pháp chủ yếu. Vấn đề khó khăn là tụ cầu rất kháng thuốc, nên làm kháng sinh đồ để chọn lọc thuốc thích hợp.
Dùng vacxin gây miễn dịch chống tụ cầu vàng cũng là một biện pháp cần thiết ở những bệnh nhân dùng kháng sinh ít kết quả. Đây là những vacxin chết và có thể được bào chế từ chủng tụ cầu vàng phân lập được ở bệnh nhân, hoặc dùng các chủng tụ cầu vàng mẫu, là những chủng thường gặp.
Rotavirus
Ở Việt Nam, từ năm 1980 mới xác định được virus Rota là căn nguyên của viêm dạ dày- ruột cấp tính, gây ỉa chảy ở trẻ em. Đây là một bệnh rất phổ biến, đứng hàng thứ hai sau nhiễm trùng đường hô hấp cấp tính ở trẻ em. Theo một số công trình nghiên cứu đã công bố trong nước, bệnh ỉa chảy do Rotavirus chiếm khoảng 27% trong số các căn nguyên gây ỉa chảy ở trẻ em. Ở những nước phát triển, tỷ lệ ỉa chảy do Rotavirus chiếm khoảng 50% trong tổng số các căn nguyên gây ỉa chảy ở trẻ em
Đặc điểm sinh học
Đặc điểm về cấu trúc
Virus có hình khối tròn, đường kính trung bình 65- 70 nm. Acid nucleic là ARN hai sợi, nằm ở trung tâm hạt virus, đường kính 38 nm và được bao bọc bởi hai lớp capsid. Các capsome của lớp trong xếp theo hình nan hoa và kéo nối với các capsome của lớp ngoài tạo nên hình vòng. Do vậy, các virus này mới có tên là Rota.
Đặc điểm về kháng nguyên
Hai lớp capsid mang đặc điểm kháng nguyên riêng biệt: lớp capsid ngoài mang kháng nguyên đặc hiệu typ. Lớp capsid trong mang kháng nguyên đặc hiệu nhóm. Nhân không mang kháng nguyên.
Rotavirus gây bệnh cho người và các Rotavirus gây bệnh cho động vật có kháng nguyên tương tự nhau nhưng không có mối liên quan về mặt kháng nguyên với các virus thuộc họ Reoviridae.

Cấu tạo của Rotavirus |
Đặc điểm nhân lên và khả năng gây bệnh
Virus vào cơ thể nhân lên chủ yếu ở niêm mạc tá tràng. Người ta đã cấy truyền virus trên hàng loạt các loại tế bào tiên phát như: tế bào ruột và bào thai người, thận bào thai lợn…nhưng tỷ lệ virus gây nhiễm giảm dần và bị mất đi sau 2- 5 lần cấy truyền.
Sức đề kháng
Virus bị bất hoạt nhanh chóng khi bị xử lý bằng EDTA. Chúng dễ bị bất hoạt ở pH <3 hoặc pH>10, nhưng có sức đề kháng tốt đối với Clo và ete, chúng bền vững sau nhiều ngày trong phân ở nhiệt độ thường.
Phân loại:
Về phân loại khoa học Rotavirus được xếp vào:
- Nhóm III: ds (RNA)
- Họ: Reoviridae
- Giống: Rotavirus
- Loài: A, B, C, D, E, F & G
Cơ chế gây bệnh
Rotavirus là căn nguyên thường gặp nhất trong bệnh ỉachảy ở trẻ em dưới 2 tuổi, đặc biệt là dưới 12 tháng. Virus độc lực xâm nhập vào cơ thể qua đường phân- miệng và nhân lên chủ yếu ở niêm mạc tá tràng, chúng phá hủy lớp tế bào trụ, do đó làm cho lớp tế bào này bị biến dạng. Vì vậy dẫn đến quá trình hấp thu của ruột bị giảm, do đó làm ứ đọng các chất trong lòng ruột, đặc biệt là carbohydrat; làm áp suất thẩm thấu tăng, kéo nước ra ngoài, gây ỉa chảy nhiều lần trong ngày và phân rất nhiều nước.
Triệu chứng lâm sàng
 |
Hình thể Rotavirus |
Giai đoạn ủ bệnh ngắn, chỉ 1-2 ngày kể từ khi virus xâm nhập vào cơ thể. Sau đó chuyển sang giai đoạn toàn phát với các triệu chứng sau:
- Ỉa chảy nhiều lần trong ngày, phân nhiều nước; rất hiếm khi có máu và đây là đặc điểm quan trọng để chẩn đoán phân biệt với ỉa chảy do vi khuẩn. Đôi khi bệnh nhân có nôn, trên lâm sàng biểu hiện mất nước nặng. Bệnh nhân thường gặp ở trẻ dưới 12 tháng và bệnh thường xảy ra vào mùa thu đông.
Chẩn đoán vi sinh vật
Xác định virus
- Bệnh phẩm: lấy phân bệnh nhân trong tuần lễ đầu của bệnh hoặc hút dịch tá tràng
- Phương pháp xét nghiệm
Quan sát trực tiếp dưới kính hiển vi điện tử để phát hiện độ lớn, hình thái và cấu trúc của hạt virus. Để phát hiện virus trực tiếp từ bệnh phẩm, người ta dùng các kỹ thuật miễn dịch như miễn dịch enzyme (ELISA), miễn dịch phóng xạ, miễn dịch huỳnh quang, ngưng kết hồng cầu thụ động, ngưng kết hạt latex.
Chẩn đoán huyết thanh học
- Bệnh phẩm: Lấy máu tĩnh mạch bệnh nhân và chắt lấy huyết thanh.
- Các phản ứng
Phản ứng ELISA, phản ứng huỳnh quang, miễn dịch phóng xạ và phản ứng kết hợp bổ thể đã được dùng để tìm kháng thể trong máu bệnh nhân. Kháng nguyên sử dụng trong các phản ứng trên có thể là hỗn dịch virus thu được từ phân đã được làm cô đặc và tinh chế hoặc là Rotavirus của bê.
Tuy vậy, bệnh ỉa chảy do Rotavirus là một bệnh cấp tính, nếu không chẩn đoán và điều trị kịp thời thì bệnh nhân có thể tử vong do mất nước và điện giải. Vì vậy, chỉ có phương pháp xác định virus trực tiếp từ bệnh phẩm là có giá trị nhất hiện nay
| |
Rotavirus dưới | kính hiển vi điện tử |
Phòng bệnh và điều trị
Phòng bệnh
Virus xâm nhập vào cơ thể bằng đường tiêu hóa, vì vậy người ta sử dụng các biện pháp sau đây:
- Vệ sinh ăn uống: sữa cho trẻ phải đảm bảo đủ các chỉ tiêu vệ sinh, dụng cụ đựng đồ ăn của trẻ phải được khử trùng cẩn thận, người mẹ phải giữ gìn vệ sinh tốt trong thời kỳ cho con bú.
- Xử lý và tẩy uế những chất thải và đồ dùng có liên quan tới bệnh nhân
Cho tới nay vẫn chưa có vacxin phòng bệnh, nhưng xu hướng hiện nay là nghiên cứu sản xuất một loại vacxin sống, giảm độc lực. Người ta đã chứng minh được rằng IgAs được hình thành ở đường tiêu hóa sau khi bệnh nhân bị bệnh có vai trò quyết định trong miễn dịch bảo vệ. Mặt khác, những thử nghiệm ở bê đã cho thấy miễn dịch bảo vệ được hình thành sau khi cho chúng uống virus sống giảm độc lực.
Điều trị
Phải bồi phụ nước và điện giải cho bệnh nhân, thường sau một tuần bệnh nhân hồi phục hoàn toàn.